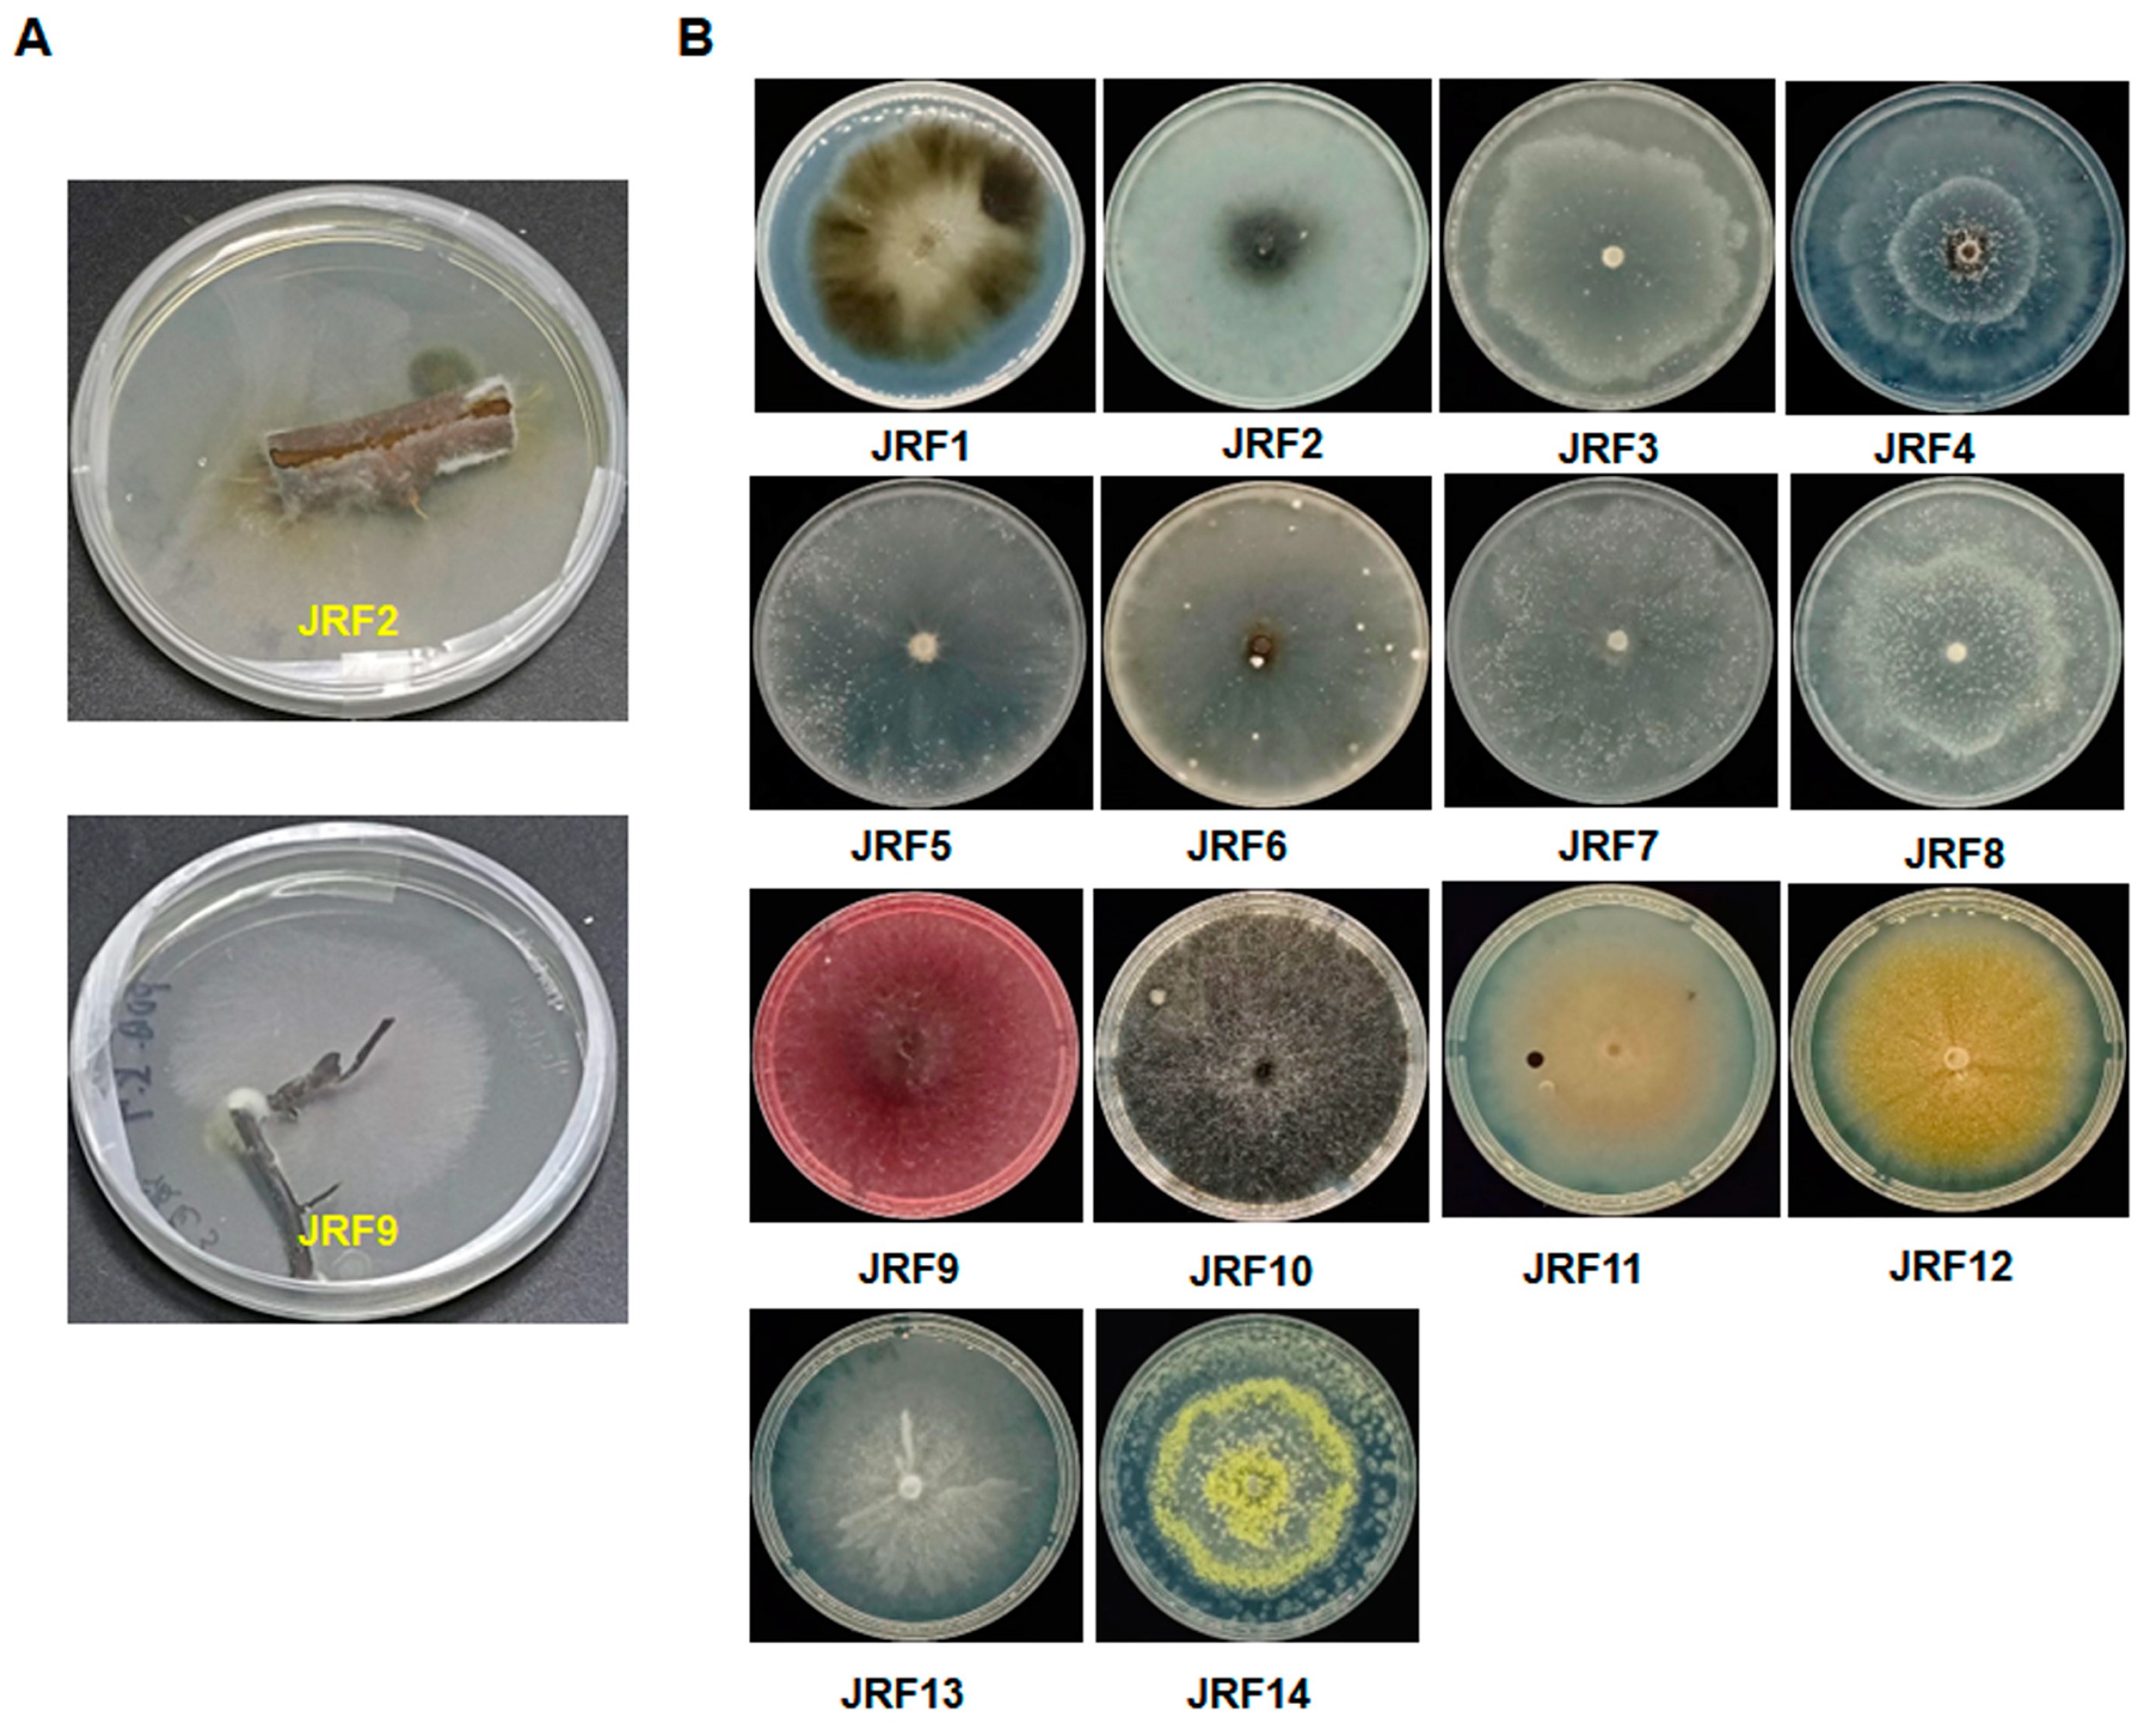
Jof 10 00120 g001

Identification and Characterization of a Plant Endophytic Fungus Paraphaosphaeria sp. JRF11 and Its Growth-Promoting Effects
Abstract
1. Introduction
2. Materials and Methods
2.1. Isolation of Endophytic Fungi
2.2. Molecular Identification of Isolated Fungi
2.3. Co-Culturation of Seedlings with Endophytic Fungi
2.3.1. Sterilization of Seeds
2.3.2. Co-Culturation
2.4. Potted Growth-Promoting Test of Endophytic Fungi
2.5. Determination of Total Nitrogen, Phosphorus, and Potassium
2.6. Determination of Total Soluble Sugar
2.6.1. Production of Standard Curve
2.6.2. Extraction of Soluble Sugar in Samples
2.6.3. Colorimetric Determination
2.7. Determination of Soluble Protein Content
2.8. Transcriptome Analysis
2.9. Statistical Analysis
3. Results
3.1. Isolation and Identification of Endophytic Fungi
3.2. Screening of Plant Growth-Promoting Endophytic Fungi
3.3. Cultivation of Paraphaosphaeria sp. JRF11 and Its Plant Growth-Promoting Effects
3.4. Colonization of Plant Roots by Paraphaosphaeria sp. JRF11
3.5. Effects of Paraphaosphaeria Strain JRF11 on the Growth of Tomato Plants
3.6. Effects of Paraphaosphaeria Strain JRF11 on Physiology of Tomato Plants
3.7. Transcriptome Analysis of Paraphaosphaeria sp. JRF11-Treated Plants
4. Discussion
Supplementary Materials
Author Contributions
Funding
Institutional Review Board Statement
Informed Consent Statement
Data Availability Statement
Conflicts of Interest
References
- Hassani, M.A.; Durán, P.; Hacquard, S. Microbial interactions within the plant holobiont. Microbiome 2018, 6, 58. [Google Scholar] [CrossRef]
- Bai, Y.; Kissoudis, C.; Yan, Z.; Visser, R.G.F.; van der Linden, G. Plant behavior under combined stress: Tomato responses to combined salinity and pathogen stress. Plant J. 2018, 93, 781–793. [Google Scholar] [CrossRef]
- Hyde, K.D.; Soytong, K. The fungal endophyte dilemma. Fungal Divers. 2008, 33, 163–173. [Google Scholar]
- Bai, B.; Liu, C.; Zhang, C.; He, X.; Wang, H.; Peng, W.; Zheng, C. Trichoderma species from plant and soil: An excellent resource for biosynthesis of terpenoids with versatile bioactivities. J. Adv. Res. 2023, 49, 81–102. [Google Scholar] [CrossRef] [PubMed]
- Hagag, A.; Abdelwahab, M.F.; Abd El-Kader, A.M.; Fouad, M.A. The endophytic Aspergillus strains: A bountiful source of natural products. J. Appl. Microbiol. 2022, 132, 4150–4169. [Google Scholar] [CrossRef]
- Hatamzadeh, S.; Rahnama, K.; White, J.F.; Oghaz, N.A.; Nasrollahnejad, S.; Hemmati, K. Investigation of some endophytic fungi from five medicinal plants with growth promoting ability on maize (Zea mays L.). J. Appl. Microbiol. 2023, 134, lxac015. [Google Scholar] [CrossRef] [PubMed]
- Huang, L.Q.; Niu, Y.C.; Su, L.; Deng, H.; Lyu, H. The potential of endophytic fungi isolated from cucurbit plants for biocontrol of soilborne fungal diseases of cucumber. Microbiol. Res. 2020, 231, 126369. [Google Scholar] [CrossRef]
- Bogas, A.C.; Cruz, F.P.N.; Lacava, P.T.; Sousa, C.P. Endophytic fungi: An overview on biotechnological and agronomic potential. Braz. J. Biol. 2022, 84, e258557. [Google Scholar] [CrossRef] [PubMed]
- Santra, H.K.; Banerjee, D. Production, Optimization, Characterization and Drought Stress Resistance by β-Glucan-Rich Heteropolysaccharide from an Endophytic Fungi Colletotrichum alatae LCS1 Isolated From Clubmoss (Lycopodium clavatum). Front. Fungal Biol. 2021, 2, 796010. [Google Scholar] [CrossRef]
- Ważny, R.; Rozpądek, P.; Jędrzejczyk, R.J.; Śliwa, M.; Stojakowska, A.; Anielska, T.; Turnau, K. Does co-inoculation of Lactuca serriola with endophytic and arbuscular mycorrhizal fungi improve plant growth in a polluted environment? Mycorrhiza 2018, 28, 235–246. [Google Scholar] [CrossRef]
- Naureen, A.; Nasim, F.H.; Choudhary, M.S.; Ashraf, M.; Grundler, F.M.W.; Schleker, A.S.S. A new endophytic fungus CJAN1179 isolated from the Cholistan desert promotes lateral root growth in Arabidopsis and produces IAA through tryptophan-dependent pathway. Arch. Microbiol. 2022, 204, 181. [Google Scholar] [CrossRef]
- Vergara, C.; Araujo, K.E.C.; Urquiaga, S.; Schultz, N.; Balieiro, F.C.; Medeiros, P.S.; Santos, L.A.; Xavier, G.R.; Zilli, J.E. Dark Septate Endophytic Fungi Help Tomato to Acquire Nutrients from Ground Plant Material. Front. Microbiol. 2017, 8, 2437. [Google Scholar] [CrossRef]
- Mathew, J.; Radhakrishnan, E.K. Endophytic Phomopsis sp. colonization in Oryza sativa was found to result in plant growth promotion and piperine production. Physiol. Plant 2017, 160, 437–446. [Google Scholar] [CrossRef]
- Trakunyingcharoen, T.; Lombard, L.; Groenewald, J.Z.; Cheewangkoon, R.; To-Anun, C.; Alfenas, A.C.; Crous, P.W. Mycoparasitic species of Sphaerellopsis, and allied lichenicolous and other genera. IMA Fungus 2014, 5, 391–414. [Google Scholar] [CrossRef]
- Cen, R.H.; Li, S.Y.; Yang, Y.B.; Yang, X.Q.; Ding, Z.T. Novel Antifungal and Antifeedant Metabolites from Penicillium chrysogenum Co-Cultured with Nemania primolutea and Aspergillus fumigatus. Chem. Biodivers. 2023, 20, e202300004. [Google Scholar] [CrossRef]
- Su, S.; Yang, X.Q.; Yang, Y.B.; Ding, Z.T. Three new fumagillol analogues and antifungal activity from Aspergillus fumigatus cocultured with Paraphaeosphaeria sp. Fitoterapia 2023, 165, 105395. [Google Scholar] [CrossRef] [PubMed]
- Li, C.S.; Sarotti, A.M.; Huang, P.; Dang, U.T.; Hurdle, J.G.; Kondratyuk, T.P.; Pezzuto, J.M.; Turkson, J.; Cao, S. NF-κB inhibitors, unique γ-pyranol-γ-lactams with sulfide and sulfoxide moieties from Hawaiian plant Lycopodiella cernua derived fungus Paraphaeosphaeria neglecta FT462. Sci. Rep. 2017, 7, 10424. [Google Scholar] [CrossRef] [PubMed]
- Del, C.R.-V.N.; de la Rosa, L.A.; Morales-Landa, J.L.; García-Fajardo, J.A.; García-Cruz, M. Phytochemical Content and Potential Health Applications of Pecan [Carya illinoinensis (Wangenh) K. Koch] Nutshell. Curr. Top. Med. Chem. 2022, 22, 150–167. [Google Scholar] [CrossRef]
- Li, G.-R.; Cao, B.-H.; Liu, W.; Ren, R.-H.; Feng, J.; Lv, D.-J. Isolation and Identification of Endophytic Fungi in Kernels of Coix lachrymal-jobi L. Cultivars. Curr. Microbiol. 2020, 77, 1448–1456. [Google Scholar] [CrossRef] [PubMed]
- Ravi, P.; Somu, P.; Acharya, D.; Gomez, L.A.; Thathapudi, J.J.; Ramachandra, Y.L.; Rudraiah, S.B.; Isaq, M.; Karua, C.S.; Arifullah, M.; et al. Isolation and Phytochemical Screening of Endophytic Fungi Isolated from Medicinal Plant Mappia foetida and Evaluation of Its In Vitro Cytotoxicity in Cancer. Appl. Biochem. Biotechnol. 2022, 194, 4570–4586. [Google Scholar] [CrossRef] [PubMed]
- Rozpądek, P.; Nosek, M.; Domka, A.; Ważny, R.; Jędrzejczyk, R.; Tokarz, K.; Pilarska, M.; Niewiadomska, E.; Turnau, K. Acclimation of the photosynthetic apparatus and alterations in sugar metabolism in response to inoculation with endophytic fungi. Plant Cell Environ. 2019, 42, 1408–1423. [Google Scholar] [CrossRef] [PubMed]
- Samapti, M.M.S.; Afroz, F.; Rony, S.R.; Sharmin, S.; Moni, F.; Akhter, S.; Ahmed, S.F.U.; Sohrab, M.H. Isolation and Identification of Endophytic Fungi from Syzygium cumini Linn and Investigation of Their Pharmacological Activities. Sci. World J. 2022, 2022, 9529665. [Google Scholar] [CrossRef] [PubMed]
- Wang, H.; Liu, Z.; Duan, F.; Chen, Y.; Qiu, K.; Xiong, Q.; Lin, H.; Zhang, J.; Tan, H. Isolation, identification, and antibacterial evaluation of endophytic fungi from Gannan navel orange. Front. Microbiol. 2023, 14, 1172629. [Google Scholar] [CrossRef]
- Thi Minh Le, T.; Thi Hong Hoang, A.; Thi Bich Le, T.; Thi Bich Vo, T.; Van Quyen, D.; Hoang Chu, H. Isolation of endophytic fungi and screening of Huperzine A-producing fungus from Huperzia serrata in Vietnam. Sci. Rep. 2019, 9, 16152. [Google Scholar] [CrossRef]
- Herawati, N.; Muharram, M.; Ummas, H. Candidate Selection for Fungi Growing Media in Dye Waste Degradation. J. Phys. Conf. Ser. 2019, 1244, 012001. [Google Scholar] [CrossRef]
- Janoušková, M.; Krak, K.; Vosátka, M.; Püschel, D.; Štorchová, H. Inoculation effects on root-colonizing arbuscular mycorrhizal fungal communities spread beyond directly inoculated plants. PLoS ONE 2017, 12, e0181525. [Google Scholar] [CrossRef] [PubMed]
- Liu, H.; Senthilkumar, R.; Ma, G.; Zou, Q.; Zhu, K.; Shen, X.; Tian, D.; Hua, M.S.; Oelmüller, R.; Yeh, K.W. Piriformospora indica-induced phytohormone changes and root colonization strategies are highly host-specific. Plant Signal. Behav. 2019, 14, 1632688. [Google Scholar] [CrossRef]
- Chen, Q.; Yu, J.J.; He, J.; Feng, T.; Liu, J.K. Isobenzofuranones and isocoumarins from kiwi endophytic fungus Paraphaeosphaeria sporulosa and their antibacterial activity against Pseudomonas syringae pv. actinidiae. Phytochemistry 2022, 195, 113050. [Google Scholar] [CrossRef] [PubMed]
- Koistinen, J.; Sjöblom, M.; Spilling, K. Total Nitrogen Determination by a Spectrophotometric Method. In Biofuels from Algae: Methods and Protocols; Spilling, K., Ed.; Springer New York: New York, NY, USA, 2020; pp. 81–86. [Google Scholar]
- Feng, S. Study on quality control of nitrogen, phosphorus and potassium in wheat grain. An Hui Nong Xue Tong Bao 2021, 27, 58–59. [Google Scholar] [CrossRef]
- Patch, A.M.; Nones, K.; Kazakoff, S.H.; Newell, F.; Wood, S.; Leonard, C.; Holmes, O.; Xu, Q.; Addala, V.; Creaney, J.; et al. Germline and somatic variant identification using BGISEQ-500 and HiSeq X Ten whole genome sequencing. PLoS ONE 2018, 13, e0190264. [Google Scholar] [CrossRef] [PubMed]
- Zhu, F.Y.; Chen, M.X.; Ye, N.H.; Qiao, W.M.; Gao, B.; Law, W.K.; Tian, Y.; Zhang, D.; Zhang, D.; Liu, T.Y.; et al. Comparative performance of the BGISEQ-500 and Illumina HiSeq4000 sequencing platforms for transcriptome analysis in plants. Plant Methods 2018, 14, 69. [Google Scholar] [CrossRef] [PubMed]
- González-Jartín, J.M.; Alfonso, A.; Sainz, M.J.; Vieytes, M.R.; Aguín, O.; Ferreiroa, V.; Botana, L.M. First report of Fusarium foetens as a mycotoxin producer. Mycotoxin Res. 2019, 35, 177–186. [Google Scholar] [CrossRef] [PubMed]
- Verkley, G.J.; Dukik, K.; Renfurm, R.; Göker, M.; Stielow, J.B. Novel genera and species of coniothyrium-like fungi in Montagnulaceae (Ascomycota). Persoonia 2014, 32, 25–51. [Google Scholar] [CrossRef] [PubMed]
- Lin, L.C.; Ye, Y.S.; Lin, W.R. Characteristics of root-cultivable endophytic fungi from Rhododendron ovatum Planch. Braz J. Microbiol. 2019, 50, 185–193. [Google Scholar] [CrossRef]
- Arminian, A.; Dehghani Bidgoli, R. Simultaneous responses of photosystem II and soluble proteins of rapeseed to cold acclimation. Cell. Mol. Biol. (Noisy-Le-Grand) 2019, 65, 37–49. [Google Scholar] [CrossRef] [PubMed]
- Rosa, M.; Prado, C.; Podazza, G.; Interdonato, R.; González, J.A.; Hilal, M.; Prado, F.E. Soluble sugars—Metabolism, sensing and abiotic stress: A complex network in the life of plants. Plant Signal. Behav. 2009, 4, 388–393. [Google Scholar] [CrossRef] [PubMed]
- Considine, M.J.; Foyer, C.H. Oxygen and reactive oxygen species-dependent regulation of plant growth and development. Plant Physiol. 2021, 186, 79–92. [Google Scholar] [CrossRef]
- Zhang, M.; Zhang, S. Mitogen-activated protein kinase cascades in plant signaling. J. Integr. Plant Biol. 2022, 64, 301–341. [Google Scholar] [CrossRef] [PubMed]
- Wang, S.; Pei, J.; Li, J.; Tang, G.; Zhao, J.; Peng, X.; Nie, S.; Ding, Y.; Wang, C. Sucrose and starch metabolism during Fargesia yunnanensis shoot growth. Physiol. Plant 2020, 168, 188–204. [Google Scholar] [CrossRef] [PubMed]
- Khalmuratova, I.; Choi, D.H.; Kim, J.G.; Lee, I.S. Endophytic Fungi of Salt-Tolerant Plants: Diversity and Ability to Promote Plant Growth. J. Microbiol. Biotechnol. 2021, 31, 1526–1532. [Google Scholar] [CrossRef]
- Khan, S.A.; Hamayun, M.; Yoon, H.; Kim, H.Y.; Suh, S.J.; Hwang, S.K.; Kim, J.M.; Lee, I.J.; Choo, Y.S.; Yoon, U.H.; et al. Plant growth promotion and Penicillium citrinum. BMC Microbiol. 2008, 8, 231. [Google Scholar] [CrossRef] [PubMed]
- Khan, M.S.; Gao, J.; Munir, I.; Zhang, M.; Liu, Y.; Moe, T.S.; Xue, J.; Zhang, X. Characterization of Endophytic Fungi, Acremonium sp., from Lilium davidii and Analysis of Its Antifungal and Plant Growth-Promoting Effects. Biomed Res. Int. 2021, 2021, 9930210. [Google Scholar] [CrossRef]
- Yan, L.; Zhu, J.; Zhao, X.; Shi, J.; Jiang, C.; Shao, D. Beneficial effects of endophytic fungi colonization on plants. Appl. Microbiol. Biotechnol. 2019, 103, 3327–3340. [Google Scholar] [CrossRef] [PubMed]
- Shah, S.; Shah, B.; Sharma, R.; Rekadwad, B.; Shouche, Y.S.; Sharma, J.; Pant, B. Colonization with non-mycorrhizal culturable endophytic fungi enhances orchid growth and indole acetic acid production. BMC Microbiol. 2022, 22, 101. [Google Scholar] [CrossRef]
- Aizaz, M.; Ahmad, W.; Asaf, S.; Khan, I.; Saad Jan, S.; Salim Alamri, S.; Bilal, S.; Jan, R.; Kim, K.M.; Al-Harrasi, A. Characterization of the Seed Biopriming, Plant Growth-Promoting and Salinity-Ameliorating Potential of Halophilic Fungi Isolated from Hypersaline Habitats. Int. J. Mol. Sci. 2023, 24, 4904. [Google Scholar] [CrossRef] [PubMed]
- Li, M.; Wang, H.; Zhao, X.; Feng, W.; Ding, G.; Quan, W. Effect of Ectomycorrhizal Fungi on the Drought Resistance of Pinus massoniana Seedlings. J. Fungi 2023, 9, 471. [Google Scholar] [CrossRef] [PubMed]
- van Dongen, J.T.; Licausi, F. Oxygen sensing and signaling. Annu. Rev. Plant Biol. 2015, 66, 345–367. [Google Scholar] [CrossRef]
- Zubrycka, A.; Dambire, C.; Dalle Carbonare, L.; Sharma, G.; Boeckx, T.; Swarup, K.; Sturrock, C.J.; Atkinson, B.S.; Swarup, R.; Corbineau, F.; et al. ERFVII action and modulation through oxygen-sensing in Arabidopsis thaliana. Nat. Commun. 2023, 14, 4665. [Google Scholar] [CrossRef] [PubMed]
- Li, L.; Guo, N.; Zhang, Y.; Yuan, Z.; Lu, A.; Li, S.; Wang, Z. Reprogramming of Fundamental miRNA and Gene Expression during the Barley-Piriformospora indica Interaction. J. Fungi 2022, 9, 24. [Google Scholar] [CrossRef] [PubMed]
- Manna, M.; Rengasamy, B.; Sinha, A.K. Revisiting the role of MAPK signalling pathway in plants and its manipulation for crop improvement. Plant Cell Environ. 2023, 46, 2277–2295. [Google Scholar] [CrossRef]
- Sharma, A.; Shahzad, B.; Rehman, A.; Bhardwaj, R.; Landi, M.; Zheng, B. Response of Phenylpropanoid Pathway and the Role of Polyphenols in Plants under Abiotic Stress. Molecules 2019, 24, 2452. [Google Scholar] [CrossRef] [PubMed]
- Qiu, C.; Sun, J.; Shen, J.; Zhang, S.; Ding, Y.; Gai, Z.; Fan, K.; Song, L.; Chen, B.; Ding, Z.; et al. Fulvic acid enhances drought resistance in tea plants by regulating the starch and sucrose metabolism and certain secondary metabolism. J. Proteom. 2021, 247, 104337. [Google Scholar] [CrossRef] [PubMed]
- Erayman, M.; Turktas, M.; Akdogan, G.; Gurkok, T.; Inal, B.; Ishakoglu, E.; Ilhan, E.; Unver, T. Transcriptome analysis of wheat inoculated with Fusarium graminearum. Front. Plant Sci. 2015, 6, 867. [Google Scholar] [CrossRef] [PubMed]

| Name | Tissue | Closest Species | Identity | Accession Number | Effect | Description of Colonies |
|---|---|---|---|---|---|---|
| JRF1 | Stem | Aureobasidium melanogenum CBS 105.22 | 98.14% | NR 159598.1 | + | The hyphae are grayish green and flocculent. The colony margin is smooth and army green. |
| JRF2 | Stem | Botryosphaeria wangensis CGMMCC 3.18744 | 100% | NR 159555.1 | / | There are grayish green punctate secreta on the surface of the colony. The hyphae are white, but the center of the colony is grayish green with a radiation line. |
| JRF3 | Stem | Diaporthe alnea CBS 146.46 | 97.52% | NR 147525.1 | - | The hyphae are white. The colony with an annular line looks like a petal; it produces few aerial hyphae. |
| JRF4 | Stem | Diaporthe celeris | 98.86% | NR 158433.1 | * | The hyphae look like white cotton and produce aerial hyphae. The colony looks like concentric circles; there is brown sediment in the center of the colony. |
| JRF5 | Stem | Diaporthe longicolla ATCC 60325 | 97.91% | NR 144924.1 | / | The hyphae look like white cotton; they produce aerial hyphae. The colony changes from white to yellow. |
| JRF6 | Stem | Diaporthe sackstonii BRIP 54669b | 98.85% | NR 147537.1 | - | The hyphae look like white cotton. There are punctate secreta and few aerial hyphae on the surface of the colony. Its margin produces pigmentation. |
| JRF7 | Stem | Diaporthe sojae CBS 139282 | 99.43% | NR 147542.1 | / | The hyphae are white, and the distribution of aerial hyphae is tight. The colony with a line looks like a petal. |
| JRF8 | Stem | Diaporthe vaccinii CBS 160.32 | 97.53% | NR 103701.1 | - | The hyphae are white. The colony with an annular line looks like a petal; the distribution of aerial hyphae is tight, but its margin produces yellow pigmentation at the end. |
| JRF9 | Root | Fusarium foetens CBS 110286 | 100% | NR 159865.1 | / | The hyphae are white and villiform. The colony is reddish brown with little aerial hyphae. |
| JRF10 | Root | Mycoleptodiscus terrestris CBS 231.53 | 99.48% | NR 145373.1 | - | The colony changes from grayish green to atrovirens. A large number of punctate granules are distributed on the surface and inside the medium. |
| JRF11 | Root | Paraphaeosphaeria sardoa CBS 501.71 | 97.81% | NR 145167.1 | + | The hyphae are white and villiform. The colony looks like concentric circles, and the margin of the colony is smooth. The growth of this fungus is slow. |
| JRF12 | Root | Penicillium javanicum CBS 341.48 | 92.16% | NR 111511.1 | * | The hyphae produce a radiation line. The colony is yellow, and the punctate granule is distributed on the surface of the colony. |
| JRF13 | Root | Pseudthielavia terricola CBS 603.97 | 99.22% | NR 165513.1 | * | The hyphae are white. The colony with a line looks like a petal and the aerial hyphae look like white cotton. |
| JRF14 | Root | Talaromyces coprophilus FMR 15199 | 99.09% | NR 172395.1 | - | The hyphae are villiform. There are yellow punctations on the surface of the colony, and they distribute like concentric circles. |
| Medium | Growth Rate (mm/d) | Sporulation Quantity |
|---|---|---|
| Potato Dextrose Agar (PDA) | 5.50 | II |
| Yeast Extract Peptone Dextrose Medium | 5.42 | I |
| Modified Melin-Norkrans Medium | 4.40 | I |
| Corn Meal Medium | 5.00 | III |
| Czapek Dox Agar Medium | 4.69 | I |
| Malt Extract Agar | 5.00 | II |
| Sabouraud Dextrose Agar Medium | 4.13 | I |
Disclaimer/Publisher’s Note: The statements, opinions and data contained in all publications are solely those of the individual author(s) and contributor(s) and not of MDPI and/or the editor(s). MDPI and/or the editor(s) disclaim responsibility for any injury to people or property resulting from any ideas, methods, instructions or products referred to in the content. |
© 2024 by the authors. Licensee MDPI, Basel, Switzerland. This article is an open access article distributed under the terms and conditions of the Creative Commons Attribution (CC BY) license (https://creativecommons.org/licenses/by/4.0/).
Share and Cite
Shan, J.; Peng, F.; Yu, J.; Li, Q. Identification and Characterization of a Plant Endophytic Fungus Paraphaosphaeria sp. JRF11 and Its Growth-Promoting Effects. J. Fungi 2024, 10, 120. https://doi.org/10.3390/jof10020120
Shan J, Peng F, Yu J, Li Q. Identification and Characterization of a Plant Endophytic Fungus Paraphaosphaeria sp. JRF11 and Its Growth-Promoting Effects. Journal of Fungi. 2024; 10(2):120. https://doi.org/10.3390/jof10020120
Chicago/Turabian StyleShan, Jie, Fangren Peng, Jinping Yu, and Qi Li. 2024. "Identification and Characterization of a Plant Endophytic Fungus Paraphaosphaeria sp. JRF11 and Its Growth-Promoting Effects" Journal of Fungi 10, no. 2: 120. https://doi.org/10.3390/jof10020120
APA StyleShan, J., Peng, F., Yu, J., & Li, Q. (2024). Identification and Characterization of a Plant Endophytic Fungus Paraphaosphaeria sp. JRF11 and Its Growth-Promoting Effects. Journal of Fungi, 10(2), 120. https://doi.org/10.3390/jof10020120

